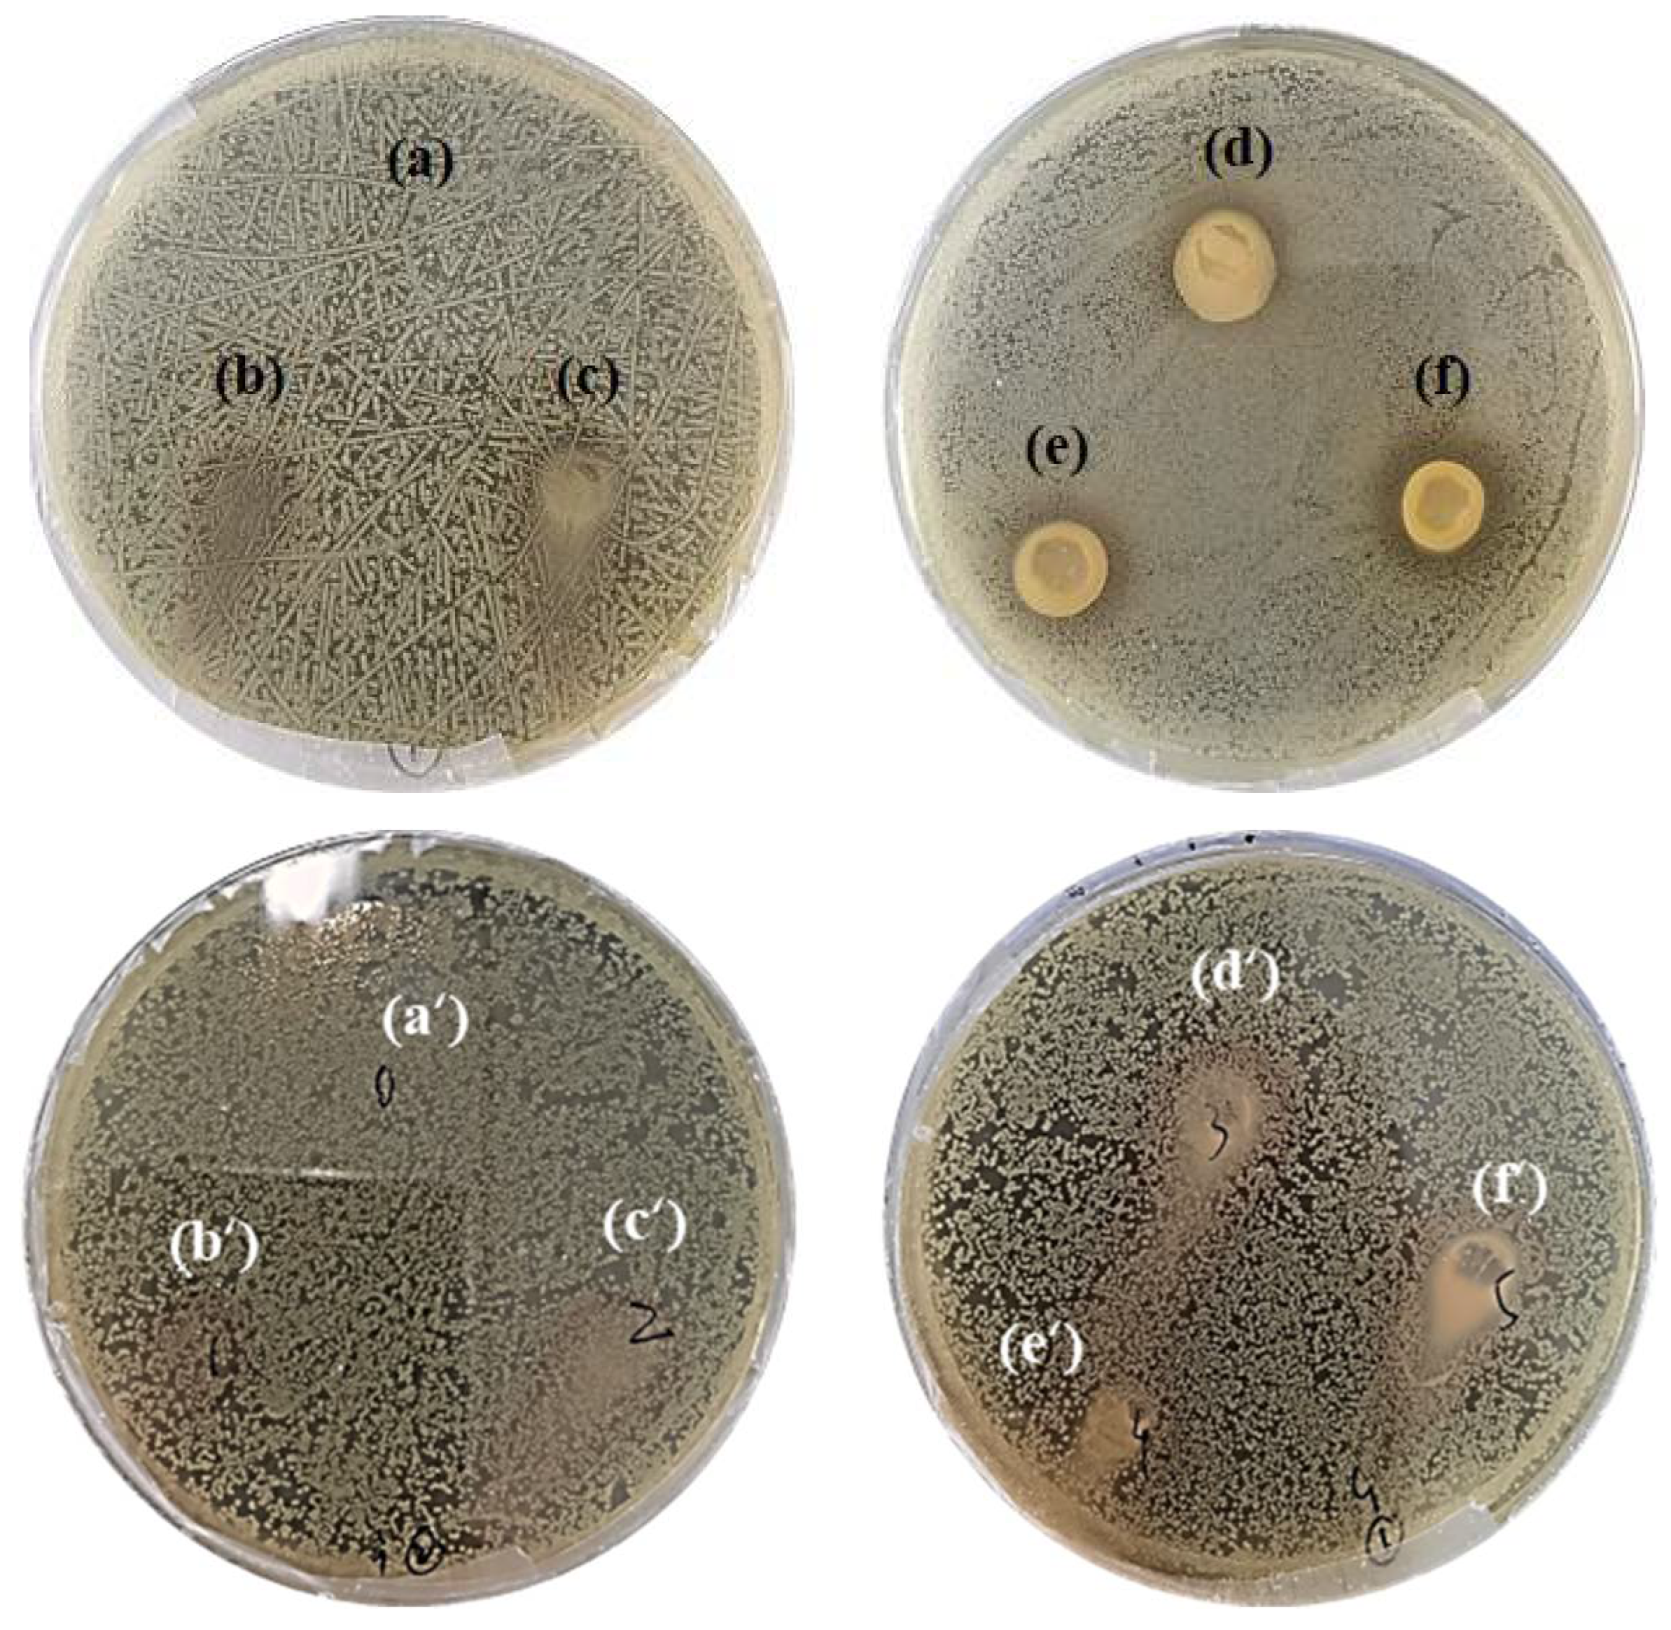

Bioactive Edible Sodium Alginate Films Incorporated with Tannic Acid as Antimicrobial and Antioxidative Food Packaging
Abstract
:1. Introduction
2. Materials and Methods
2.1. Materials
2.2. Fabrication of Edible Sodium Alginate Films
2.3. Characterization
2.3.1. Fourier Transform Infrared Spectroscopy (FTIR)
2.3.2. Light Transmission and Transparency
2.3.3. Color Parameters
2.3.4. Water Vapor Permeability (WVP)
2.3.5. Tensile Strengths (TS)
2.3.6. X-ray Diffraction (XRD)
2.3.7. Thermogravimetric Analysis (TGA)
2.4. Antioxidant Properties
2.5. Antimicrobial Activity
2.6. Statistical Analysis
3. Results and Discussion
3.1. Functional Groups and Chemical Bonds Characterization
3.2. Light Transmission and Transparency
3.3. Color Parameter
3.4. Water Vapor Permeability (WVP)
3.5. Mechanical Properties
3.6. X-ray Diffraction (XRD)
3.7. Thermal Stability Analysis
3.8. Antioxidant and Antimicrobial Activity
4. Conclusions
Author Contributions
Funding
Data Availability Statement
Conflicts of Interest
References
- Chen, F.; Chi, C. Development of pullulan/carboxylated cellulose nanocrystal/tea polyphenol bionanocomposite films for active food packaging. Int. J. Biol. Macromol. 2021, 186, 405–413. [Google Scholar] [CrossRef]
- Asgher, M.; Qamar, S.A.; Bilal, M.; Iqbal, H.M.N. Bio-based active food packaging materials: Sustainable alternative to conventional petrochemical-based packaging materials. Food Res. Int. 2020, 137, 109625. [Google Scholar] [CrossRef] [PubMed]
- Chen, J.; Wu, A.; Yang, M.; Ge, Y.; Pristijono, P.; Li, J.; Xu, B.; Mi, H. Characterization of sodium alginate-based films incorporated with thymol for fresh-cut apple packaging. Food Control 2021, 126, 108063. [Google Scholar] [CrossRef]
- Feng, M.; Yu, L.; Zhu, P.; Zhou, X.; Liu, H.; Yang, Y.; Zhou, J.; Gao, C.; Bao, X.; Chen, P. Development and preparation of active starch films carrying tea polyphenol. Carbohydr. Polym. 2018, 196, 162–167. [Google Scholar] [CrossRef]
- Aloui, H.; Deshmukh, A.R.; Khomlaem, C.; Kim, B.S. Novel composite films based on sodium alginate and gallnut extract with enhanced antioxidant, antimicrobial, barrier and mechanical properties. Food Hydrocoll. 2021, 113, 106508. [Google Scholar] [CrossRef]
- Halim, A.L.A.; Kamari, A.; Phillip, E. Chitosan, gelatin and methylcellulose films incorporated with tannic acid for food packaging. Int. J. Biol. Macromol. 2018, 120, 1119–1126. [Google Scholar] [CrossRef] [PubMed]
- Zhang, C.; Yang, Z.; Shi, J.; Zou, X.; Zhai, X.; Huang, X.; Li, Z.; Holmes, M.; Daglia, M.; Xiao, J. Physical properties and bioactivities of chitosan/gelatin-based films loaded with tannic acid and its application on the preservation of fresh-cut apples. LWT 2021, 144, 111223. [Google Scholar] [CrossRef]
- Li, P.; Sirviö, J.A.; Haapala, A.; Khakalo, A.; Liimatainen, H. Anti-oxidative and UV-absorbing biohybrid film of cellulose nanofibrils and tannin extract. Food Hydrocoll. 2019, 92, 208–217. [Google Scholar] [CrossRef]
- Leite, L.S.F.; Pham, C.; Bilatto, S.; Azeredo, H.M.C.; Cranston, E.D.; Moreira, F.K.; Mattoso, L.H.C.; Bras, J. Effect of Tannic Acid and Cellulose Nanocrystals on Antioxidant and Antimicrobial Properties of Gelatin Films. ACS Sustain. Chem. Eng. 2021, 9, 8539–8549. [Google Scholar] [CrossRef]
- Zhang, W.; Jiang, W. Antioxidant and antibacterial chitosan film with tea polyphenols-mediated green synthesis silver nanoparticle via a novel one-pot method. Int. J. Biol. Macromol. 2020, 155, 1252–1261. [Google Scholar] [CrossRef]
- Wu, H.; Lei, Y.; Zhu, R.; Zhao, M.; Lu, J.; Xiao, D.; Jiao, C.; Zhang, Z.; Shen, G.; Li, S. Preparation and characterization of bioactive edible packaging films based on pomelo peel flours incorporating tea polyphenol. Food Hydrocoll. 2019, 90, 41–49. [Google Scholar] [CrossRef]
- Dou, L.; Li, B.; Zhang, K.; Chu, X.; Hou, H. Physical properties and antioxidant activity of gelatin-sodium alginate edible films with tea polyphenols. Int. J. Biol. Macromol. 2018, 118, 1377–1383. [Google Scholar] [CrossRef] [PubMed]
- Hasheminya, S.-M.; Mokarram, R.R.; Ghanbarzadeh, B.; Hamishekar, H.; Kafil, H.S.; Dehghannya, J. Development and characterization of biocomposite films made from kefiran, carboxymethyl cellulose and Satureja Khuzestanica essential oil. Food Chem. 2019, 289, 443–452. [Google Scholar] [CrossRef]
- di Donato, P.; Taurisano, V.; Poli, A.; d’Ayala, G.G.; Nicolaus, B.; Malinconinco, M.; Santagata, G. Vegetable wastes derived polysaccharides as natural eco-friendly plasticizers of sodium alginate. Carbohydr. Polym. 2020, 229, 115427. [Google Scholar] [CrossRef] [PubMed]
- Halász, K.; Csóka, L. Black chokeberry (Aronia melanocarpa) pomace extract immobilized in chitosan for colorimetric pH indicator film application. Food Packag. Shelf Life 2018, 16, 185–193. [Google Scholar] [CrossRef]
- Abbasi, A.R.; Sohail, M.; Minhas, M.U.; Khaliq, T.; Kousar, M.; Khan, S.; Hussain, Z.; Munir, A. Bioinspired sodium alginate based thermosensitive hydrogel membranes for accelerated wound healing. Int. J. Biol. Macromol. 2020, 155, 751–765. [Google Scholar] [CrossRef] [PubMed]
- Faidi, A.; Lassoued, M.A.; Becheikh, M.E.H.; Touati, M.; Stumbé, J.-F.; Farhat, F. Application of sodium alginate extracted from a Tunisian brown algae Padina pavonica for essential oil encapsulation: Microspheres preparation, characterization and in vitro release study. Int. J. Biol. Macromol. 2019, 136, 386–394. [Google Scholar] [CrossRef]
- Wei, W.; Li, J.; Han, X.; Yao, Y.; Zhao, W.; Han, R.; Li, S.; Zhang, Y.; Zheng, C. Insights into the adsorption mechanism of tannic acid by a green synthesized nano-hydroxyapatite and its effect on aqueous Cu(II) removal. Sci. Total Environ. 2021, 778, 146189. [Google Scholar] [CrossRef] [PubMed]
- Zhang, Z.-Y.; Sun, Y.; Zheng, Y.-D.; He, W.; Yang, Y.-Y.; Xie, Y.-J.; Feng, Z.-X.; Qiao, K. A biocompatible bacterial cellulose/tannic acid composite with antibacterial and anti-biofilm activities for biomedical applications. Mater. Sci. Eng. C 2020, 106, 110249. [Google Scholar] [CrossRef]
- Han, G.; Wen, S.; Wang, H.; Feng, Q. Interaction mechanism of tannic acid with pyrite surfaces and its response to flotation separation of chalcopyrite from pyrite in a low-alkaline medium. J. Mater. Res. Technol. 2020, 9, 4421–4430. [Google Scholar] [CrossRef]
- Li, Y.; Shi, S.; Cao, H.; Cao, R. Robust antifouling anion exchange membranes modified by graphene oxide (GO)-enhanced Co-deposition of tannic acid and polyethyleneimine. J. Membr. Sci. 2021, 625, 119111. [Google Scholar] [CrossRef]
- Gwak, M.A.; Hong, B.M.; Park, W.H. Hyaluronic acid/tannic acid hydrogel sunscreen with excellent anti-UV, antioxidant, and cooling effects. Int. J. Biol. Macromol. 2021, 191, 918–924. [Google Scholar] [CrossRef]
- Moraczewski, K.; Malinowski, R.; Łączny, D.; Macko, M. Surface modification of maize stem with polydopamine and tannic acid coatings. Surf. Interfaces 2021, 26, 101319. [Google Scholar] [CrossRef]
- Liu, J.; Wang, H.; Wang, P.; Guo, M.; Jiang, S.; Li, X.; Jiang, S. Films based on κ-carrageenan incorporated with curcumin for freshness monitoring. Food Hydrocoll. 2018, 83, 134–142. [Google Scholar] [CrossRef]
- Liang, X.; Cao, K.; Li, W.; Li, X.; McClements, D.J.; Hu, K. Tannic acid-fortified zein-pectin nanoparticles: Stability, properties, antioxidant activity, and in vitro digestion. Food Res. Int. 2021, 145, 110425. [Google Scholar] [CrossRef]
- Júnior, L.M.; Rodrigues, P.R.; da Silva, R.G.; Vieira, R.P.; Alves, R.M.V. Sustainable Packaging Films Composed of Sodium Alginate and Hydrolyzed Collagen: Preparation and Characterization. Food Bioprocess Technol. 2021, 14, 2336–2346. [Google Scholar] [CrossRef]
- Kaczmarek, B. Improving Sodium Alginate Films Properties by Phenolic Acid Addition. Materials 2020, 13, 2895. [Google Scholar] [CrossRef]
- Sharma, A.; Verma, C.; Mukhopadhyay, S.; Gupta, A.; Gupta, B. Development of sodium alginate/glycerol/tannic acid coated cotton as antimicrobial system. Int. J. Biol. Macromol. 2022, 216, 303–311. [Google Scholar] [CrossRef] [PubMed]
- Ramakrishnan, R.K.; Wacławek, S.; Černík, M.; Padil, V.V.T. Biomacromolecule assembly based on gum kondagogu-sodium alginate composites and their expediency in flexible packaging films. Int. J. Biol. Macromol. 2021, 177, 526–534. [Google Scholar] [CrossRef]
- Júnior, L.M.; Vieira, R.P.; Anjos, C.A.R. Kefiran-based films: Fundamental concepts, formulation strategies and properties. Carbohydr. Polym. 2020, 246, 116609. [Google Scholar] [CrossRef]
- Kaewprachu, P.; Osako, K.; Rungraeng, N.; Rawdkuen, S. Characterization of fish myofibrillar protein film incorporated with catechin-Kradon extract. Int. J. Biol. Macromol. 2018, 107, 1463–1473. [Google Scholar] [CrossRef]
- Shankar, S.; Rhim, J.-W. Preparation and characterization of agar/lignin/silver nanoparticles composite films with ultraviolet light barrier and antibacterial properties. Food Hydrocoll. 2017, 71, 76–84. [Google Scholar] [CrossRef]
- Wang, H.; Gong, X.; Miao, Y.; Guo, X.; Liu, C.; Fan, Y.-Y.; Zhang, J.; Niu, B.; Li, W. Preparation and characterization of multilayer films composed of chitosan, sodium alginate and carboxymethyl chitosan-ZnO nanoparticles. Food Chem. 2019, 283, 397–403. [Google Scholar] [CrossRef]
- Yong, H.; Bi, F.; Liu, J.; Qin, Y.; Bai, R.; Liu, J. Preparation and characterization of antioxidant packaging by chitosan, D-α-tocopheryl polyethylene glycol 1000 succinate and baicalein. Int. J. Biol. Macromol. 2020, 153, 836–845. [Google Scholar] [CrossRef]
- Martins, J.T.; Cerqueira, M.A.; Bourbon, A.I.; Pinheiro, A.C.; Souza, B.W.S.; Vicente, A.A. Synergistic effects between κ-carrageenan and locust bean gum on physicochemical properties of edible films made thereof. Food Hydrocoll. 2012, 29, 280–289. [Google Scholar] [CrossRef]
- Tan, W.; Zhang, J.; Zhao, X.; Li, Q.; Dong, F.; Guo, Z. Preparation and physicochemical properties of antioxidant chitosan ascorbate/methylcellulose composite films. Int. J. Biol. Macromol. 2020, 146, 53–61. [Google Scholar] [CrossRef]
- Zheng, K.; Xiao, S.; Li, W.; Wang, W.; Chen, H.; Yang, F.; Qin, C. Chitosan-acorn starch-eugenol edible film: Physico-chemical, barrier, antimicrobial, antioxidant and structural properties. Int. J. Biol. Macromol. 2019, 135, 344–352. [Google Scholar] [CrossRef]
- Shao, Y.; Wu, C.; Wu, T.; Yuan, C.; Chen, S.; Ding, T.; Ye, X.; Hu, Y. Green synthesis of sodium alginate-silver nanoparticles and their antibacterial activity. Int. J. Biol. Macromol. 2018, 111, 1281–1292. [Google Scholar] [CrossRef]
- Ghobashy, M.M.; Bassioni, G. pH stimuli-responsive poly(acrylamide-co-sodium alginate) hydrogels prepared by γ-radiation for improved compressive strength of concrete. Adv. Polym. Tech. 2018, 37, 2123–2133. [Google Scholar] [CrossRef]
- Guerretta, F.; Magnacca, G.; Franzoso, F.; Ivanchenko, P.; Nisticò, R. Sodium alginate conversion into char via pyrolysis at the onset temperature. Mater. Lett. 2019, 234, 339–342. [Google Scholar] [CrossRef]
- Liu, S.; Li, Y.; Li, L. Enhanced stability and mechanical strength of sodium alginate composite films. Carbohydr. Polym. 2017, 160, 62–70. [Google Scholar] [CrossRef] [PubMed]
- Amjadi, S.; Almasi, H.; Ghorbani, M.; Ramazani, S. Preparation and characterization of TiO2NPs and betanin loaded zein/sodium alginate nanofibers. Food Packag. Shelf Life 2020, 24, 100504. [Google Scholar] [CrossRef]
- Miao, Z.; Zhang, Y.; Lu, P. Novel active starch films incorporating tea polyphenols-loaded porous starch as food packaging materials. Int. J. Biol. Macromol. 2021, 192, 1123–1133. [Google Scholar] [CrossRef] [PubMed]

| Sample ID | SA (g) | TA (g) | Glycerol (g) | Water (g) |
|---|---|---|---|---|
| SA-TA0 | 1.0 | 0 | 0.2 | 99 |
| SA-TA1 | 1.0 | 0.2 | 0.2 | 99 |
| SA-TA2 | 1.0 | 0.4 | 0.2 | 99 |
| SA-TA3 | 1.0 | 0.6 | 0.2 | 99 |
| SA-TA4 | 1.0 | 0.8 | 0.2 | 99 |
| SA-TA5 | 1.0 | 1.0 | 0.2 | 99 |
| Film | L* | a* | b* | ΔE* | WI | C* |
|---|---|---|---|---|---|---|
| SA-TA0 | 41.878 ± 0.096 | −0.06 ab ± 0.0115 | −0.485 f ± 0.0129 | — | 41.875 ± 0.096 | 0.489 f ± 0.0116 |
| SA-TA1 | 41.738 ± 0.129 | 0.105 a ± 0.0129 | 0.538 e ± 0.0171 | 1.056 e ± 0.0307 | 41.735 ± 0.129 | 0.548 ef ± 0.0182 |
| SA-TA2 | 41.538 ± 0.350 | −0.00575 ab ± 0.00675 | 0.685 d ± 0.0465 | 1.262 d ± 0.0519 | 41.533 ± 0.349 | 0.685 d ± 0.0465 |
| SA-TA3 | 41.82 ± 0.502 | −0.12 ab ± 0.00816 | 1.46 c ± 0.102 | 2.000 c ± 0.0861 | 41.801 ± 0.500 | 1.465 c ± 0.102 |
| SA-TA4 | 41.872 ± 0.310 | −0.175 b ± 0.01 | 2.392 b ± 0.0613 | 2.896 b ± 0.0620 | 41.823 ± 0.312 | 2.398 b ± 0.0609 |
| SA-TA5 | 41.618 ± 0.314 | −0.238 b ± 0.005 | 3.125 a ± 0.010 | 3.639 a ± 0.0143 | 41.533 ± 0.314 | 3.134 a ± 0.0101 |
Publisher’s Note: MDPI stays neutral with regard to jurisdictional claims in published maps and institutional affiliations. |
© 2022 by the authors. Licensee MDPI, Basel, Switzerland. This article is an open access article distributed under the terms and conditions of the Creative Commons Attribution (CC BY) license (https://creativecommons.org/licenses/by/4.0/).
Share and Cite
Li, H.; Liu, C.; Sun, J.; Lv, S. Bioactive Edible Sodium Alginate Films Incorporated with Tannic Acid as Antimicrobial and Antioxidative Food Packaging. Foods 2022, 11, 3044. https://doi.org/10.3390/foods11193044
Li H, Liu C, Sun J, Lv S. Bioactive Edible Sodium Alginate Films Incorporated with Tannic Acid as Antimicrobial and Antioxidative Food Packaging. Foods. 2022; 11(19):3044. https://doi.org/10.3390/foods11193044
Chicago/Turabian StyleLi, Han, Chen Liu, Jingrong Sun, and Shanshan Lv. 2022. "Bioactive Edible Sodium Alginate Films Incorporated with Tannic Acid as Antimicrobial and Antioxidative Food Packaging" Foods 11, no. 19: 3044. https://doi.org/10.3390/foods11193044
APA StyleLi, H., Liu, C., Sun, J., & Lv, S. (2022). Bioactive Edible Sodium Alginate Films Incorporated with Tannic Acid as Antimicrobial and Antioxidative Food Packaging. Foods, 11(19), 3044. https://doi.org/10.3390/foods11193044

